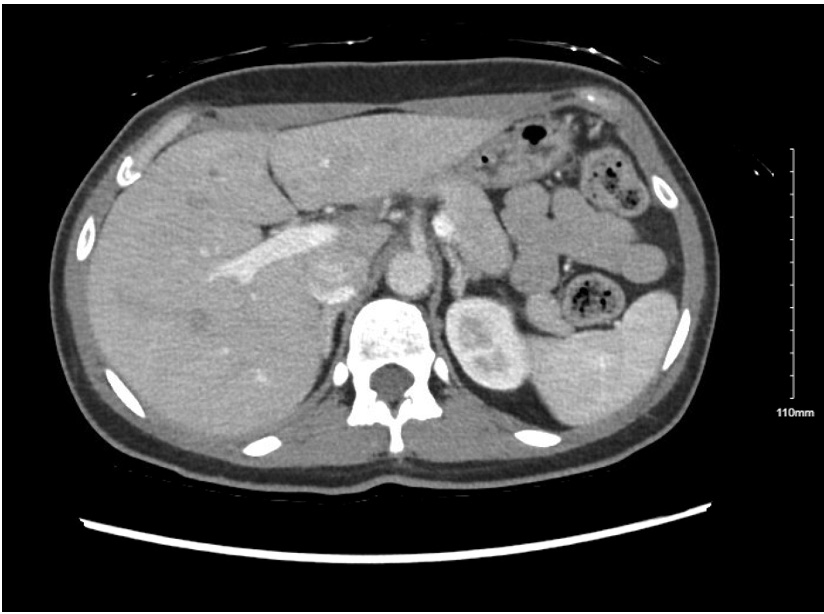
4351484_File000001.jpg

Final ID: FR406
A Subtle Case of Primary Aldosteronism
Abstract Body: We present a case of a 40-year-old woman with migraines and a history of pre-eclampsia referred to Complex Hypertension Clinic who experienced recurrent episodes of severe hypertension with associated headaches, palpitations, and a syncopal episode. At presentation, she was on high doses of three antihypertensives. Given the severity of her hypertension and her age, a secondary hypertension work-up was initiated. She had a normal echocardiogram and renal artery duplex ultrasound. During a hospitalization for syncope, she was hypokalemic with a prolonged QTc that normalized with potassium supplementation. A loop recorder was implanted and she was referred for evaluation in electrophysiology clinic, where her loop recorder was negative for arrythmia. In Complex Hypertension clinic, secondary work-up was completed that was negative for OSA and pheochromocytoma. Ambulatory blood pressure monitoring revealed well-controlled home readings, concerning for white coat effect, though she continued to have symptomatic hypertensive episodes. Her aldosterone-to-renin ratio (ARR) was elevated at 62.8, prompting Endocrinology referral, where a repeat ARR was 5.9 with a renin activity of 1.52. Due to discordant results, a saline suppression test and repeat ARRs off losartan were performed (Figure 1). The aldosterone level did not suppress with normal saline infusion. A computed tomography scan [AK1] with adrenal protocol revealed a 1.1 cm x 0.7 cm left adrenal nodule (Figure 2). Adrenal vein sampling was then performed, which showed left-lateralization of aldosterone secretion without contralateral suppression, concordant with a left adrenal nodule. This case highlights the challenges in diagnosing primary aldosteronism. Despite classic signs, such as hypokalemia, biochemical testing was often normal, requiring high clinical suspicion. Specifically, our patient’s repeat renin was not clearly suppressed, which led to the decision to discontinue her angiotensin receptor blocker (ARB) to clarify the diagnosis and accurately interpret ARRs. Furthermore, diagnosis and treatment involved a multidisciplinary team including endocrinology, radiology, electrophysiology, and cardiology. We engaged our patient in shared decision-making and she opted to pursue adrenalectomy. At two-month follow-up, she no longer required antihypertensives, with clinic BP in the 130s/97 and home BP in the 100–110s/70s. Her migraine medications were stopped, and she reported resolution of headaches.
More abstracts on this topic:
A Longitudinal 20-year Analysis Indicates Acceleration of Cardiometabolic Comorbidities on Dementia Risk
Lihua Huang, Danish Muhammad, Auyeung Tw, Jenny Lee, Kwok Timothy, Abrigo Jill, Wei Yingying, Lo Cecilia, Fung Erik
Additive effect of nighttime blood pressure on left ventricular strain in patients with primary aldosteronism evaluated via cardiac magnetic resonance tissue trackingWan Jindong, Liu Sen, Yang Yi, Wang Xinquan, Wang Dan, Zhou Peng, Wang Peijian